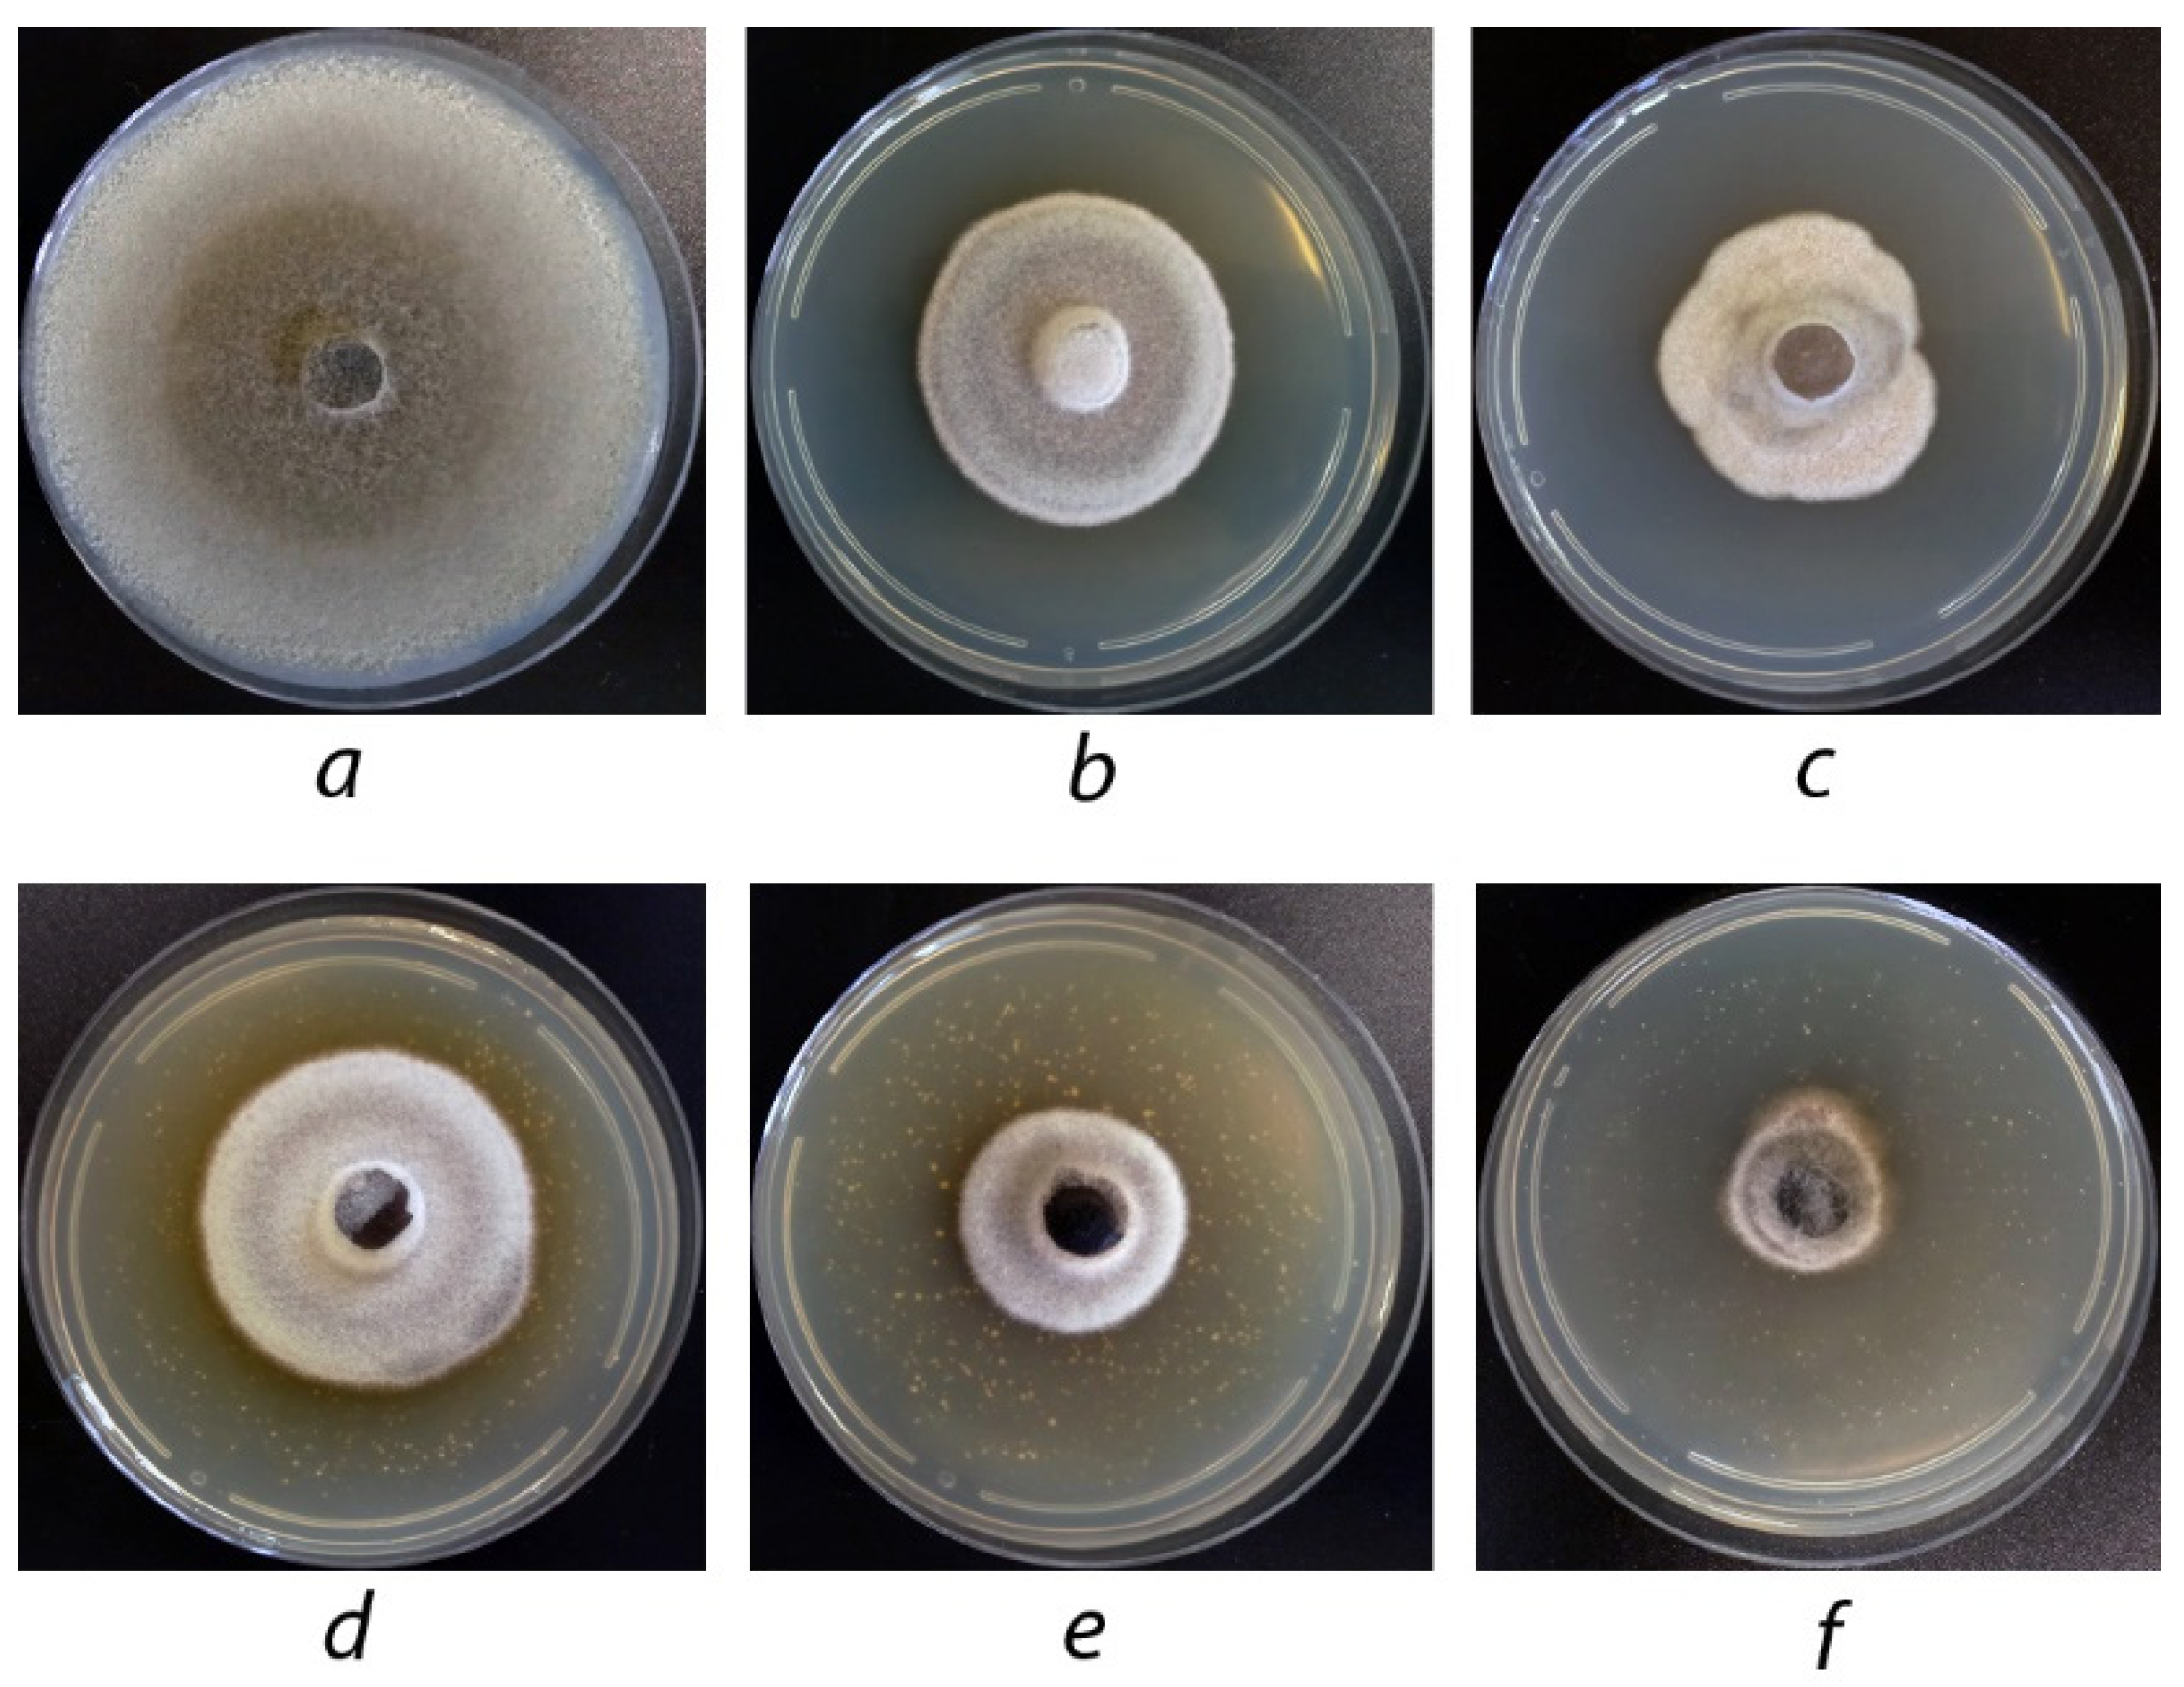
Agriculture 12 01488 g009 550

1. Introduction
Potato (
Solanum tuberosum L.) is the fourth major agricultural crop after corn, wheat, and rice, which is used in many countries as the main foodstuff [
1,
2]. In 2019, the global potato production in the world reached 370.5 million tons [
3]. In recent decades, potato is also considered as a promising technical raw product to produce ethanol, starch, sugar syrups, antioxidants, and other compounds. One of the reasons for poor potato yield is widespread viral, fungal, and bacterial diseases which infect plants and are stored in the tubers. In many cases, chemical changes in the infected tubers make them unsuitable for processing.
Along with the late blight of potato, early blight of potato represents one of the most harmful and common potato diseases causing significant reduction in the tuber yield and quality [
4,
5]. According to some data, poor control of this disease may result in yield losses reaching 50–58% [
6].
Early blight is caused by necrotrophic imperfect fungi from the genus
Alternaria, among which the most common and dangerous are
A. solani Sorauer and three small spore species,
A. alternata (Fr) Keissl,
A. infectoria E.G. Simmous, and
A. tenuissima (Kunze) Wiltshire [
7]. The primary infection sources include conidia, chlamydospores, and mycelial debris overwintered in soil or plant debris [
8].
Alternaria fungi mainly infect plants weakened by viral diseases or suffering from the deficiency of mineral nutrition. The morphological symptoms of a plant infection with
Alternaria fungi are very similar for different fungal species [
9]. The pathogen easily penetrates into host tissues due to its ability to produce exogenous lytic enzymes, among which cellulases and pectinases play a major role in the virulence of the pathogen [
10]. In the early stages, no visible manifestations of infection are observed. The first symptoms of diseases are manifested at the beginning of flowering and at the early tuber formation phase. The fungus infects mainly leaves and sometimes stems and tubers. First, dry brown lesions with concentric rings appear on the bottom and then on the top leaves, thus decreasing the photosynthetic area of the leaves [
11]. Necrotic lesions in the form of slightly depressed strokes or cankers may appear on the petioles and stems. The surface of infected tubers has brown or black slightly depressed lesions of irregular shape with well-distinguished edges. Spores from leaf lesions are easily carried for large distances by the wind and become a new infection source [
8].
Along with potato,
Alternaria fungi also infect other agricultural crops including cabbage, tomato, eggplant, squash, carrot, onion, sunflower, and pepper [
4,
12].
According to some forecasts, future global climate changes will promote an increase in a number of plant pathogen species that determines the importance of a search of efficient, but environmentally safe, methods of plant disease control [
13,
14]. Thus, the use of different classes of fungicides to manage plant pathogens is an essential part of modern agriculture [
6,
15].
Chemical protection methods take a leading position in the arsenal of approaches used to control the early blight of potato, especially in the systems of industrial-scale production of this crop [
16]. However, in spite of its biological and economic efficiency, the common use of numerous synthetic fungicides resulted in the reduction in their efficiency because of the development of pathogen resistance to their active ingredients [
17,
18]. Moreover, the resulting accumulation of fungicide residues in the soil and water negatively influences the environment and the health of humans and animals [
17,
19,
20]. Thus, the search for alternative and efficient ways to control the development of plant pathogens in general and, in particular,
Alternaria fungi, is a very relevant task.
However, from a practical point of view, a complete rejection of modern fungicides is irrational since their application allows farmers to manage the development of fungal crop diseases [
21]. One of the possible ways to reduce the xenobiotic load on agrobiocoenoses is by combining chemical protective agents with biocontrol methods [
15].
The preparations used for the biological control of fungal pathogens represent natural microbial strains or their metabolites possessing strong antifungal activity [
22]. Such biofungicides can be successively used in integrated plant protection systems due to their efficiency, selectivity, and relative safety for all ecological niches (soil, plants, insects, animals, and humans) [
15,
23]. Among potential biocontrol agents, special attention is paid to
Penicillium fungi which produce various biologically active compounds [
24] and possess wide fungicidal activity [
25,
26]. There are also some studies reporting the antiviral, immunomodulating, and growth-stimulating activity of preparations based on
Penicillium fungi; these properties make it possible to use such biopreparations as a part of integrated crop protection systems [
27,
28,
29].
Previously, using a multistep UV mutagenesis followed by selection, the authors of this study obtained a
P. chrysogenum strain F-4876D [
30]. The past study showed the ability of this strain to suppress the growth and development of
Sclerotinia sclerotiorum (Lib.) de Bary and plant pathogenic
Fusarium fungi (
F. oxysporum,
F. graminearum,
F. avenaceum, and
F. culmorum) under the conditions of both the combination of a dry mycelium biomass (DMP) of
P. chrysogenum F-4876D with azoxystrobin and the use of DMP only [
30,
31]. Thus, taking into account the significance of potato as an agricultural crop in Russia and on a global scale, it was interesting to study the antifungal activity of DMP, used alone or in combination with several commercial fungicides (azoxystrobin-, tebuconazole-, fludioxonil-, and difenoconazole-based formulations used for potato protection) to control
A. solani.
2. Materials and Methods
2.1. Reagents
Fungal strains included in the study were grown and maintained using commercial nutrient media, such as potato dextrose agar (PDA; Condalab, Madrid, Spain) and Czapek Dox agar, granulated (HiMedia Laboratories, India).
Commercial fungicides used in the study included: Quadris® (Syngenta, Basel, Switzerland) containing 250 g/L of azoxystrobin; Folicur® EC 250 (Bayer AG, Leverkusen, Germany) containing 250 g/L of tebuconazole; Maxim® SC (Syngenta, Saint-Pierre-la-Garenne, France) containing 25 g/L of fludioxonil; and Skor® EC (Syngenta, Basel, Switzerland) containing 250 g/L of difenoconazole.
Inorganic salts, glycerin, and glucose were purchased from Acros Organics (Geel, Belgium). Agar and meat peptone were manufactured by Difco (Detroit, MI, USA) and HiMedia Laboratories (Mumbai, India), respectively. Skimmed deodorized soybean flour was manufactured by Soyanta 200 (Irkutsk, Russia).
2.2. Microorganisms
A P. chrysogenum VKM F-4876D strain from the work collection of the Laboratory of Biotechnology of Physiologically Active Compounds of the Federal Research Center “Fundamentals of Biotechnology” (Moscow, Russia) was used to produce antifungal preparations. The A. solani strain used in the study was isolated from potato leaves (cv. Zhukovsky ranny) collected in the Tula region (Russia). Strains of A. solani 100053 and A. alternata 100125 were obtained from the State Collection of Plant Pathogenic Microorganisms of the All-Russian Research Institute of Phytopathology (Bolshie Vyazemy, Russia).
2.3. Nutrient Media and Cultivation Conditions
2.3.1. Composition of Nutrient Media
A P. chrysogenum VKM F-4876D strain was maintained on the solid medium of the following composition (g/L): agar, 20; glucose, 30; glycerol, 70; soybean flour, 10; meat peptone, 10; NaNO3, 2; MgSO4·7H2O, 1 (pH 6.3–6.5).
The A. solani isolate and the strains of A. solani 100053 and A. alternata 100125 were maintained on a ready PDA medium at 4 °C for one month and then were reinoculated onto fresh medium. For long-term storage, the fungus was put into 50% glycerol and stored at –20 °C. For taxonomic identification, potato carrot agar was used. Potato and carrot (20 g of each component) were cut into small pieces, added to 500 mL of desalinized water, and boiled for 1 h. Then vegetables were passed through a sieve and supplemented with 20 g of agar and water up to a final volume of 1 L. No pH regulation was performed. The resulting medium was sterilized at 121 °C for 20 min and then poured into Petri plates.
2.3.2. Cultivation on Liquid Nutrient Medium
A. solani was cultivated on liquid potato medium. Peeled potato (200 g) was boiled for 1 h in 1 L of demineralized water. The resulted potato broth was filtered through a cotton–gauze filter and supplemented with water (up to a volume of 1 L) and glucose (20 g/L). The medium pH was adjusted to 6.0–6.2. The medium was poured into 250 mL flasks (50 mL per flask) and autoclaved for 30 min at 121 °C.
To obtain inoculate, 10 mL of a sterile physiological solution was added into a tube with
A. solani isolate. The top mycelial layer was accurately taken using a microbiological loop and transferred into flasks with liquid potato medium. The flasks were incubated for 72 h on an Innova 44 incubation shaker (New Brunswick, Germany) at 24 °C and 220 rpm. After completion of the process, the culture was reinoculated into similar flasks with the same medium containing DMP suspension prepared as described in
Section 2.6.1. The volume of the transferred inoculate was 10% of the total incubation volume, and the final DMP concentration was 0.075, 0.3, and 2.5 g/L. The state of mycelium was evaluated after 48 h of incubation.
Cultivation of
P. chrysogenum VKM F-4876D and DMP production were performed as described in [
30].
2.4. A. solani Isolation and Identification
A. solani isolation into a pure culture was carried out according to [
32] with some modifications. Small leaf fragments (10 mm × 10 mm) with early blight lesions were sterilized using 0.1% sodium hypochlorite for 1–2 min and then thrice washed with distilled water and dried on a sterile filter paper under sterile conditions. Then each leaf fragment was placed at the center of a Petri plate with PDA medium and incubated for 2–3 days at 24 °C in the dark until the appearance of mycelium.
Small (5 mm × 5 mm) mycelium-containing agar blocks were cut from the plates, placed at the center of Petri plates with the same medium, and cultivated under the same conditions. The resulting samples were used to obtain monoconidial isolates grown on Petri plates with potato carrot agar under the same cultivation conditions with alternating light and dark periods. Identification of
A. solani was carried out using colonies grown on potato carrot agar and the Simmons guide [
33] via a microscope at 100× magnification and analysis of the presence or absence of spore chains, branching types, and forms of conidia.
Molecular identification of
A. solani isolate was carried out at the Molecular Diagnostics Laboratory of the “Fundamentals of Biotechnology” Federal Research Center of the Russian Academy of Sciences (Moscow, Russia). DNA isolation was performed according to [
34] with addition of 20–50 U of zymolase per sample. Concentration of the obtained DNA preparation was 30–50 μg/mL with only trace amounts of RNA (<1%). To perform PCR followed by the sequencing of PCR fragments of the ribosomal operon, the ITS5–LR5 primer system [
35,
36] was used. This system provides amplification of the DNA region including the intergenic region and genes encoding 5.8S RNA and a part of the 28S RNA. The obtained PCR products were analyzed using electrophoresis in 2% agarose at the electric field intensity of 6 V/cm. Isolation of PCR products from agarose gel and their purification were carried out using a Wizard PCR Preps DNA purification system (Promega, Madison, WI, USA) according to manufacturer recommendations. Sequencing of the obtained PCR fragments was carried out according to Sanger et al. [
37] using a BigDye terminator v.3.1 kit (Applied Biosystems Inc., Foster City, CA, USA) and an Applied Biosystems 3730 DNA analyzer (Applied Biosystems Inc., Foster City, CA, USA). The sequencing was performed from two directions using both amplifying and internal primers.
2.5. Study of Membrane Leakage
A. solani was grown on a liquid potato glucose medium as described in
Section 2.3.2. After 72 h incubation, fungal mycelium (10%
v/
v) was transferred into similar flasks with medium and grown for 24 h under the same conditions. The obtained mycelium was filtered using a Bunsen flask, Buchner funnel, and filter cloth then washed with physiological solution and thoroughly squeezed. The fungal biomass was distributed between 12 flasks (3 g of crude weight per flask); each flask contained 50 mL of distilled water and DMP at the final concentrations of 0.01, 0.1, and 1.0 g/L. Flasks containing a fungal biomass suspended in DMP-free water were used as a control. The flasks were incubated for 172 h under conditions similar to those used for pathogen growth. Electrical conductivity was measured after 0, 48, 96, 120, 148, and 172 h of incubation using a universal measuring instrument Kelilong PHT-026 PH/TDS/EC (Kelilong Electron Co., Ltd., Fuan, China). The relative electrical conductivity was determined using the following formula:
where Δ
K is the difference between the electrical conductivity measured at the given time interval and the initial electrical conductivity (prior mycelium addition), and
K0 is the electrical conductivity of distilled water.
2.6. Antifungal Activity Evaluation Using a Radial Growth Method
2.6.1. Preparation of DMP Suspension
Five grams of DMP was added to 50 mL of sterile physiological solution then mixed on an Innova 44 shaker for 1 h at 24 °C and 220 rpm.
2.6.2. Preparation of Agar Medium Containing DMP, Fungicide, or Their Combination
Ready DMP suspension and/or fungicide solution was added to sterilized PDA medium using a sterile pipette up to a required final concentration. The resulting media were thoroughly mixed and poured into Petri plates. Plates with the pathogen grown on PDA without DMP and fungicide were used as a control.
2.6.3. Evaluation of Antifungal Activity and Synergism
The radial growth evaluation assay was carried out as described in [
30]. Inoculated Petri plates were incubated at 24 °C for 14 days. Colony diameters were measured on the 3rd, 7th, and 14th days of incubation. Antifungal activity (AFA) of the tested preparations was calculated using the following formula:
where
DE and
DC are colony diameters in the experimental and control variants, respectively (mm).
A possible synergistic effect was determined using Limpel’s formula [
38]:
where
EE is the expected summarized (additive) effect of application of both DMP and fungicide (%),
ER is the effect experimentally obtained for a joint application of both compounds (%),
X and
Y are inhibiting activities provided by each of the tested compounds separately (%). If
ER >
EE, then the interaction of the compounds is considered to be synergistic.
2.7. Evaluation of Antifungal Activity of DMP on Potato Leaves
Detached 30-day potato leaves were submerged into a DMP suspension or sterile desalinized water (control variant) for 15 min and then transferred onto a filter paper under sterile conditions and slightly dried. Then leaves were transferred onto a sterile filter paper 80% moistened with sterile water and placed at the center of Petri plate (three leaves per plate). The surface of each leaf was pricked by sterile needle, and a spore suspension of
A. solani (1 × 10
4 spores/mL) was applied onto a pricked place. Plates with leaves were incubated in a wet chamber at 24 °C for 5 days, and a visual examination of the resulted lesions was performed. The percent disease incidence (PDI) was calculated using the following formula [
39]:
where
N is the number of infected leaves, and
N0 is the total number of leaves used in the experiment.
Both control and treated variants included 15 leaves each. The experiment was carried out with three replications.
2.8. Data Treatment
Each experiment on the evaluation of fungal colony growth in the presence of DMP, fungicide, or their combination was repeated three times, each with three replications. Data obtained in the experiments were analyzed using STATISTICA 6.0 software (StatSoft Inc., Tulsa, OK, USA). Mean values and standard errors were calculated. Significant differences between treatments and controls were determined using a t-test for independent variables at p ≤ 0.05.
3. Results
3.1. A. solani Identification
The
A. solani isolate was identified using morphological criteria proposed by the Simmons guide [
33] with allowance for features of conidial chain formation and spore morphology. Morphological examination was carried out in comparison with the
A. solani 100053 and
A. alternata 100125 strains identified and stored at the State Collection of Plant Pathogenic Microorganisms of the All-Russian Research Institute of Phytopathology (Bolshie Vyazemy, Russia).
Cultivated on potato carrot agar, the studied isolate was characterized by morphological traits similar to those of A. solani 100053 except for some differences in the form and color tints of colonies. The isolate showed rapid-growing grey colonies of a felt-like appearance, whereas colonies of A. solani 100053 were rather dark grey. Under the microscope, both cultures showed their morphological similarity. Yellow-brown conidia were single and rarely on chains of two. Mature conidia were oblong, up to 105–115 × 17–25 μm in size, and had 7–11 transverse septa and 1–2 longitudinal septa (in several transverse segments). The beaks were mainly unbranched, sometimes consisting of two branches and very rarely consisting of three branches and were 60–118 μm in length. The performed morphological comparison made it possible to suppose the studied isolate was close to or belonged to the genus Alternaria.
The species identification of a sample was additionally performed using molecular methods. Using the ITS5–LR5 primer system, a nucleotide sequence of a DNA region containing the intergenic region and genes encoding 5.8S RNA and a part of 28S RNA was identified (
Figure S1, Supplementary Materials). According to the results of the BLAST analysis, the studied sample was the most similar to
A. solani NL03003 (99.93% similarity level; see
Table S1 in Supplementary Materials).
Thus, based on the micro- and macromorphological traits of the isolate as well as the results of its molecular identification, the conclusion was made that it belongs to the A. solani species.
3.2. Effect of DMP Content in the Cultivation Medium on the Growth Inhibition of A. solani
A possible correlation between the DMP content in the medium and the level of
A. solani growth inhibition (antifungal effect) was examined using the radial growth method. The effect was evaluated after a 7-day cultivation, when pathogen colonies grew up to plate edges. The results of the in vitro experiment are shown in
Figure 1.
A significant (82.4–100%) suppression of pathogen growth and development was observed within the DMP concentration range of 5–7.5 g/L. At the minimal DMP concentration (0.5 g/L), the observed antifungal effect on the 7th day of incubation did not exceed 28.5%. Using probit analysis, the DMP concentration causing 50% pathogen suppression was determined as 1.26 g/L.
In the course of further
A. solani growth on PDA containing 5 g/L DMP (15–20 days of cultivation), morphological changes of the pathogen colonies were observed, such as changes in the mycelium color and pubescence level compared to the control. The results of the microscopic examination of some zones of the mycelium showed differences in its structure (thickness and septation) and are shown in
Figure 2. One should also note an increased number of gas vacuoles in the cells of the fungus grown on PDA containing 5 g/L DMP (
Figure 3).
The results of the microscopic study of a 72 h
A. solani mycelium grown on liquid potato medium containing DMP at concentrations 0.3, 3.0, and 6.0 g/L are presented in
Figure 4. The DMP presence in the medium resulted in both the inhibition of
A. solani growth and morphological changes in the structure of fungal hyphae with maximum manifestation at the DMP concentration of 6.0 g/L (
Figure 4d). In this case, hyphae are often septated, thickened, and deformed compared to the control (
Figure 4a).
3.3. Effect of DMP on the Membrane Leakage in A. solani Mycelium
The effect of DMP on the membrane integrity in
A. solani cells was evaluated via changes in the relative electrical conductivity according to [
40]. A comparison of the control and experimental variants showed that DMP interaction with
A. solani cells results in a significant release of electrolytes; the higher the DMP concentration, the more significant the effect (
Figure 5). For example, 172 h incubation of
A. solani in the presence of 1 g/L DMP resulted in a doubled increase (from 515 to 1050) in the relative electroconductivity of a medium compared to the control. Therefore, metabolites from DMP are able to break the integrity of pathogen cell membranes and their normal functioning.
3.4. Study of Antifungal Activity of DMP (1 g/L) Combined with Different Fungicides against A. solani
The DMP concentration chosen for this experiment was 1 g/L. The study included four different fungicides, azoxystrobin (0.1–10 mg/L), fludioxonil (0.01–5 mg/L), tebuconazole (0.1–10 mg/L), and difenoconazole (0.01–5 mg/L), which are widely used for potato and tomato protection against main fungal pathogens including
A. solani. The results of the experiments are shown in
Figure 6,
Figure 7,
Figure 8 and
Figure 9.
Up to the 7th day of the experiment, azoxystrobin and fludioxonil demonstrated high inhibiting activity towards
A. solani within the concentration ranges of 5–10 and 1–5 mg/L, respectively (
Figure 6). Up to the 14th day of the experiment, the pathogen covered the whole Petri plate surface in variants with the presence of each fungicide alone; at the same time, a combination of DMP (1 g/L) and any of these two fungicides still provided inhibition of pathogen growth and development. On the 7th day of the experiment, a significant antifungal effect was observed in all combined variants including those with minimal fungicide concentrations; this effect also remained in the next period for variants with maximal fungicide concentrations (
Figure 7).
A comparison of
EE and
ER values calculated for the 3rd and 7th days of the experiment showed that the real antifungal effect (
ER) of the DMP combination with either azoxystrobin or fludioxonil in the whole range of their concentrations was equal to or insignificantly (up to 17%) exceeded their summarized effect (
EE) calculated according to formula (2) (see
Section 2.6.3). On the 14th day of the experiment, the difference between
ER and
EE calculated for the maximal fungicide concentrations (5 and 10 mg/L for azoxystrobin and 1 and 5 mg/L for fludioxonil) was significant, reaching 20–76% depending on the fungicide.
Similar results were observed for the in vitro study of the antifungal effect of DMP combined with two other triazole-based fungicides. Significant inhibiting activity against
A. solani for the whole period of observations was registered for tebuconazole and difenoconazole at the concentration ranges of 5–10 and 1–5 mg/L, respectively (
Figure 8). Combining these fungicides with DMP also provided a significant suppression of pathogen growth (
Figure 9); this effect still remained on the 14th day of the experiment even for variants with low fungicide concentrations (1 and 0.1 mg/L for tebuconazole and difenoconazole, respectively). In the case of this experiment, the calculated
EE value coincided with the experimental level of antifungal activity (
ER).
3.5. Study of Antifungal Activity of DMP (2 g/L) Combined with Fungicides (0.01 and 0.1 mg/L) against A. solani
In the next stage of the study, the effect of the combined application of DMP and the four fungicides tested on the growth and development of A. solani was evaluated for other concentration combinations. The tested combinations included DMP (2 g/L) and the following fungicide dosages: 0.1 and 1 mg/L for azoxystrobin; and 0.01 and 0.1 mg/L for fludioxonil, difenoconazole, and tebuconazole.
Based on the obtained results (
Figure 10), we can conclude that the combination of 2 g/L DMP and fungicides taken at minimal dosages (0.01–0.1 mg/L) in this study provides a significant inhibition of pathogen growth and development for the whole observation period.
3.6. Growth-Inhibiting Activity of DMP against Alternaria solani on Detached Potato Leaves
The results of the laboratory evaluation of DMP antifungal activity against
A. solani on detached potato leaves are shown in
Figure 11 and
Figure 12.
The treatment of potato leaves with the water solution of DMP (1 g/L) resulted in a four-fold increase in the fraction of intact leaves with no signs of infection (46.7% vs. 11.1% in the control). Moreover, treated samples also showed a three-fold reduction in the number of leaves with an insignificant affection level (13.3% vs. 44.5% in the control). Finally, the number of severely affected leaves in the control twice exceeded that in the treated sample. Thus, potato leaf treatment with 1 g/L DMP inhibits the growth and development of A. solani.
4. Discussion
Recently, the main attention in the field of potato protection against diseases has been focused on environmentally safe and efficient technologies. Nevertheless, the application of various fungicides which differ in their structure and mechanisms of action still remains to be the main tool in disease management, especially under the conditions of intensive agriculture.
The use of chemical fungicides to control crop diseases is reasonable from both economic and biological points of view. However, the common use of large volumes of fungicides has resulted in the reduction in their efficiency due to the development of fungicide-resistant strains of pathogens [
10,
17,
21,
41,
42] and the significant accumulation of fungicide residues in soil, water, and agricultural products [
43,
44]. In view of the aforementioned facts, the development of environmentally safe preparations, which would enhance the protective effect of modern fungicides applied using the recommended minimal concentrations and reduce their selective action on plant pathogen populations resulting in the appearance of resistant forms, represents a very important task.
Contact and systemic fungicides, such as ubiquinone oxidase inhibitors (QoIs, strobilurins), DMI fungicides inhibiting 14α-demethylase (CYP51) (triazoles), as well as fungicides activating osmotic signal transduction pathways (phenylpyrroles) are widely used to control the early blight of potato and tomato caused by Alternaria fungi. Our study included such fungicides as azoxystrobin, fludioxonil, tebuconazole, and difenoconazole which differ in their biological effects towards target plant pathogens.
In this study, the questions raised included the ability of DMP to suppress the growth and development of
A. solani as well as to increase the sensitivity of this pathogen to fungicides. DMP obtained from VKM F-4876D has been previously shown to suppress the growth and development of
Sclerotinia sclerotiorum (Lib.) de Bary [
31] and several plant pathogenic
Fusarium fungi (
F. oxysporum, F. graminearum, F. avenaceum, and
F. culmorum) [
30] when used both alone and in combination with azoxystrobin. The current study showed that DMP also possesses a significant antifungal activity against
A. solani. According to the data shown in
Figure 1, incubation of this pathogen on the medium supplemented with 7.5 g/L DMP resulted in complete growth inhibition; in the case of a lower DMP concentration (5 g/L), some morphophysiological changes of the pathogen colonies were observed.
Penicillium fungi are known as valuable sources of various biologically active compounds, such as alkaloids, antibiotics, hormones, etc. [
45,
46,
47]. Previously, it was shown that a culture broth of
P. chrysogenum VKM F-4876D contained 6-demethylmevinolin (mevastatin) which is known for its ability to inhibit the key stage of sterol biosynthesis. The antimicrobial properties of statins in relation to a wide range of pathogenic yeasts and fungi were also reported [
48]. The mechanism of action of this group of compounds is based on their ability to inhibit hydroxymethyl glutaryl-CoA. This results in impaired ergosterol biosynthesis in fungi and therefore, changes in the cell membrane properties responsible for the maintenance of cell homeostasis and finally, fungal growth inhibition [
49]. A double increase in relative electrical conductivity (
Figure 3) as well as observed changes in the structure of mycelium grown in the presence of DMP on both solid (
Figure 2) and liquid (
Figure 4) media can be considered as evidence of an impaired integrity of the fungal cell membranes under the action of the metabolites contained in DMP (including mevastatin).
Our study showed that DMP alone possesses a significant antifungal activity at concentrations exceeding 1.0 g/L so this concentration was used for further experiments. The results presented in
Figure 6 and
Figure 8 allow us to conclude that the combination of 1 g/L DMP and azoxystrobin (1.0 mg/L), fludioxonil (1 and 5 mg/L), difenoconazole (0.1–5 mg/L), and tebuconazole (1–10 mg/L) significantly inhibits the growth and development of
A. solani for up to 14 days. Due to the combined use of a biopreparation and a fungicide, the effect obtained may be synergetic or additive. For all experimental variants, the real antifungal activity (
ER) coincided or exceeded (by 10–15% on average) the theoretical additive activity (
EE) calculated by Limpel’s formula. The only exception was observed for the combination of 1 g/L DMP and fludioxonil at a dosage of 1–5 mg/L: the
ER value up to the 14th day of the experiment exceeded the
EE value by 3.75–4.8 times (
Figure 6).
A significant antifungal effect maintained for the whole period of observation was observed for the combination of 2 g/L DMP with fungicides taken at dosages which did not provide any antifungal effect on the 7th–14th days of the experiment (0.1–1.0 mg/L of azoxystrobin or 0.01–0.1 mg/L of fludioxonil, difenoconazole, or tebuconazole). These data show the high practical potential of DMP combined with low concentrations of fungicides to control
A. solani on potato; the observed prolongation of pathogen suppression may provide the opportunity for less frequent fungicidal treatments of potato without a decrease in their total efficiency. This effect may be explained by an increase in the
A. solani sensitivity to fungicides caused by metabolites contained in DMP. The mechanism of this effect may include an impairment of cell membrane integrity due to ergosterol biosynthesis inhibition as well as the activation of metabolic processes resulting in the generation and accumulation of reactive oxygen species capable of breaking the cell and vacuolar membranes of fungal cells causing osmotic stress and apoptosis [
50].
The protective effect of DMP against A. solani observed after the treatment of detached potato leaves with spore suspension of the pathogen confirmed the antifungal effect of DMP in in vitro observations. However, since the results obtained in such laboratory tests are not always reproduced in plants, our results require further confirmation under greenhouse and field conditions.